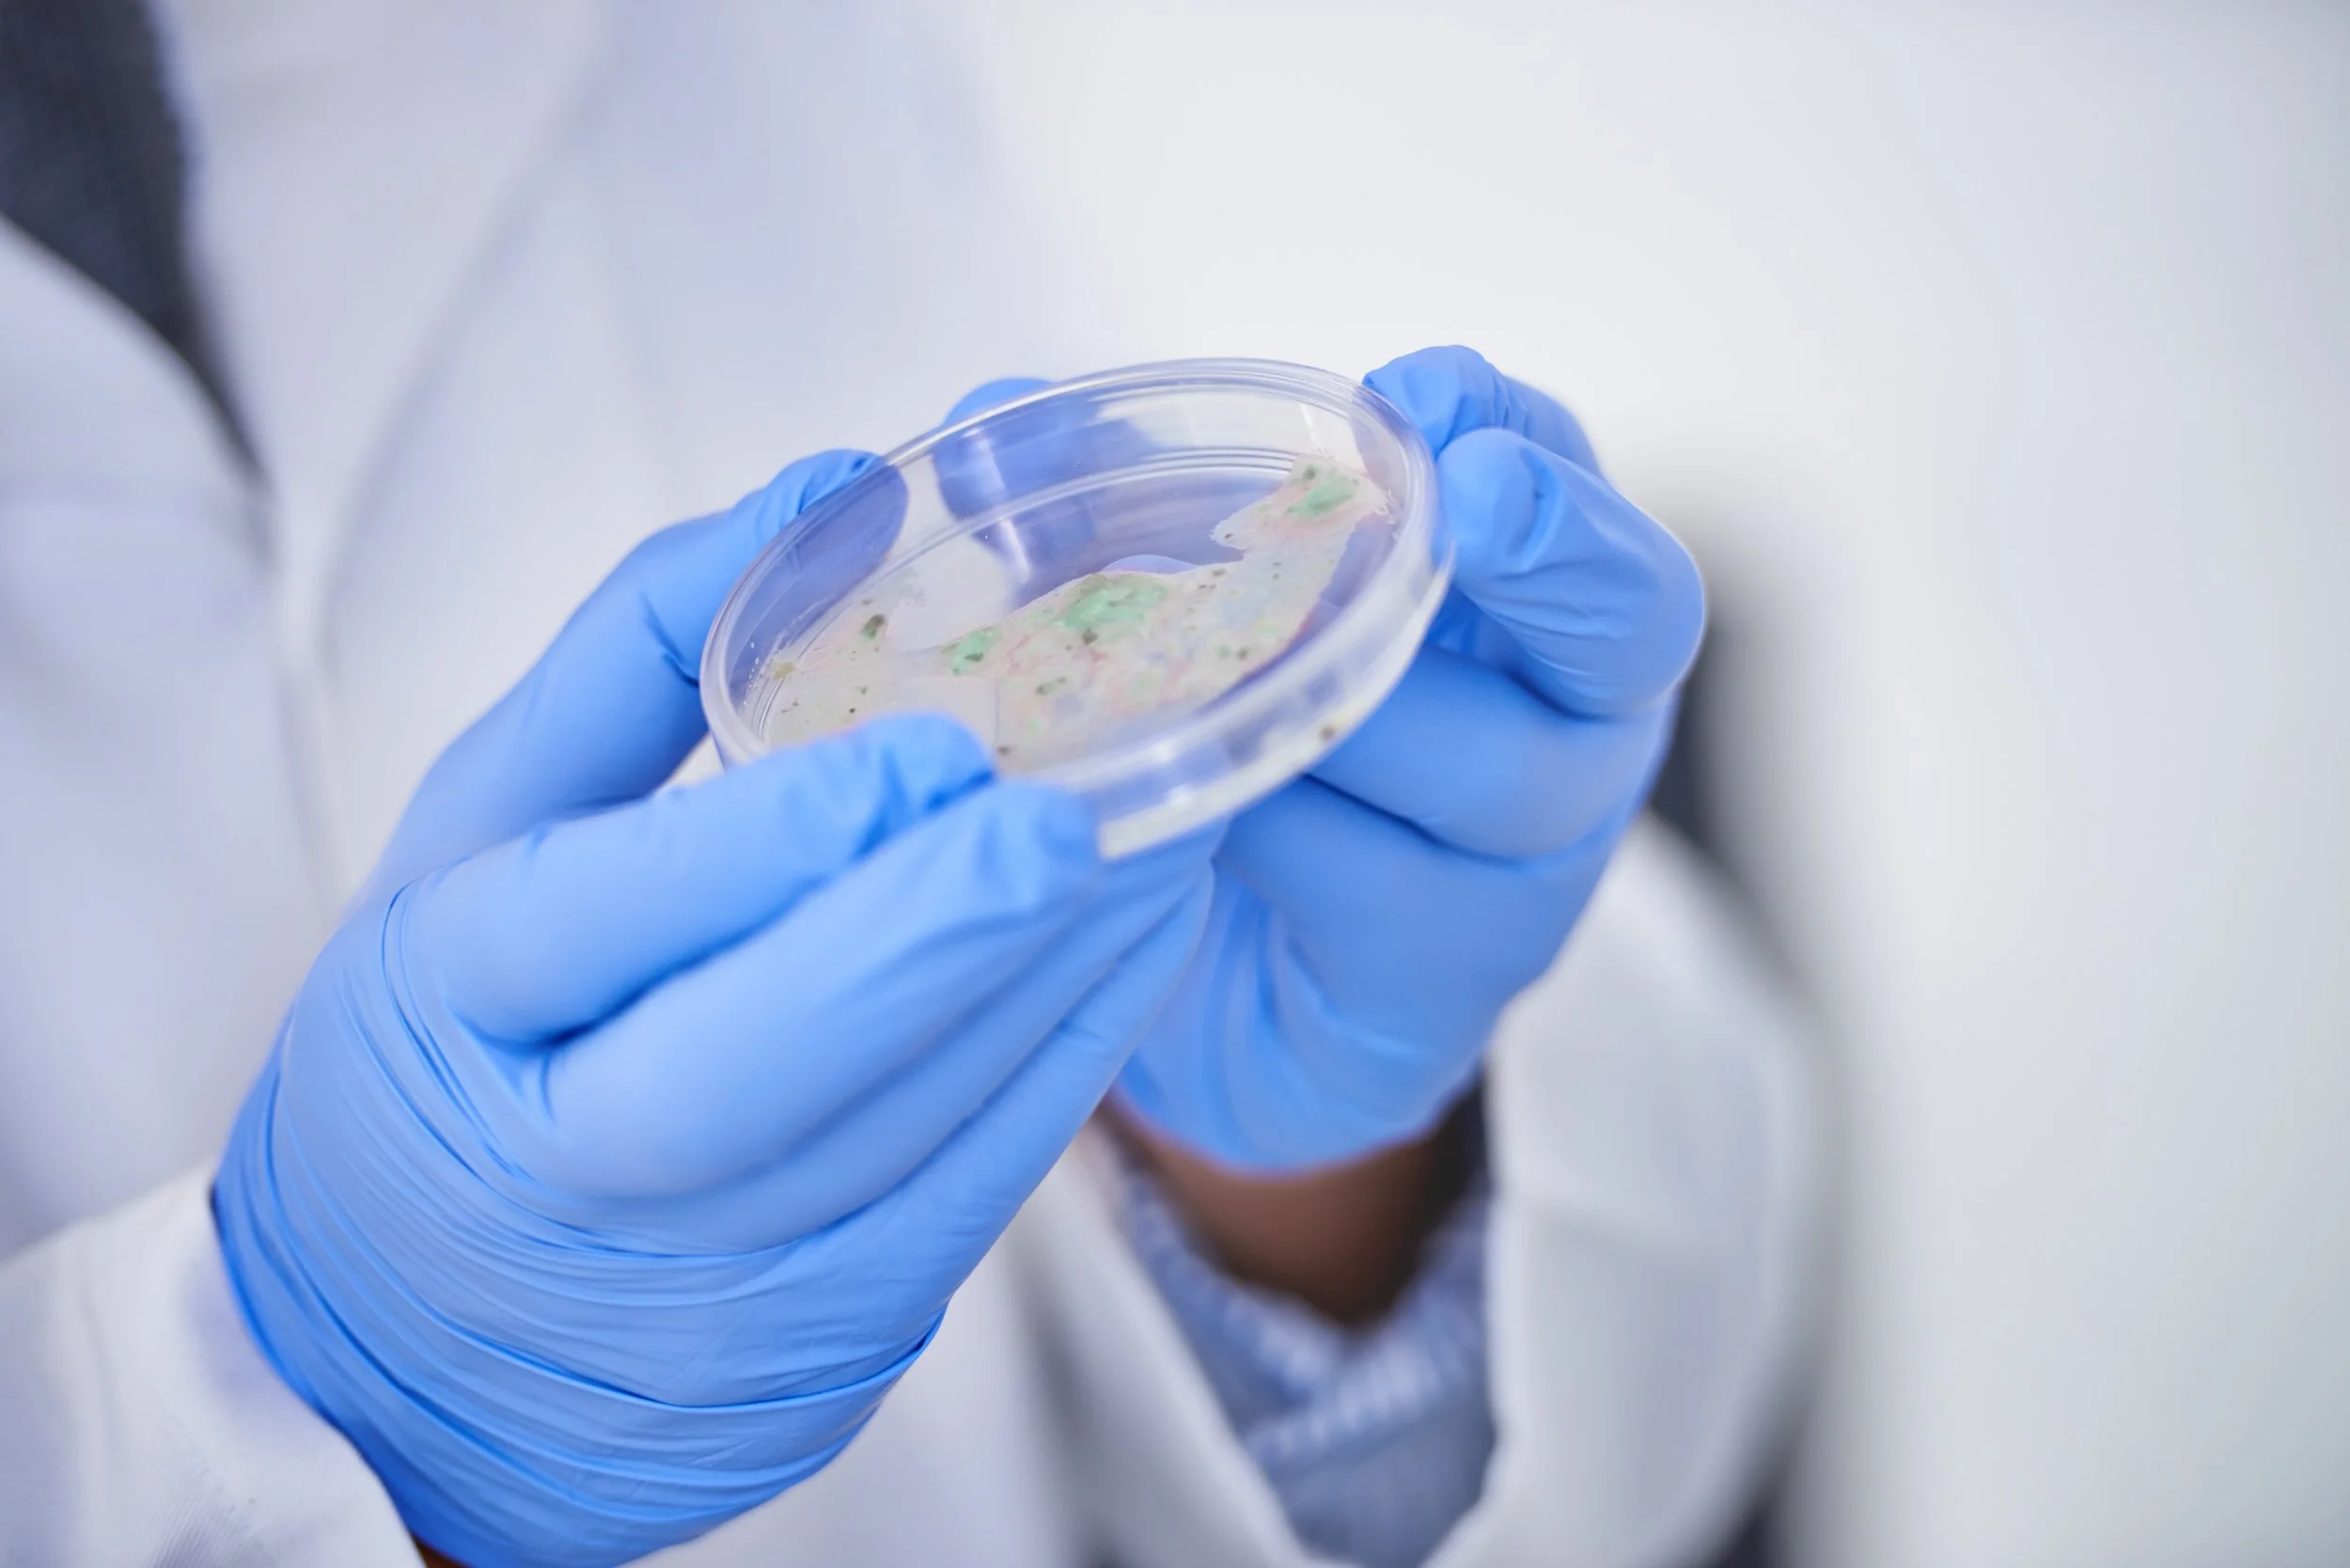

Avilabs Testing
At Avilabs, we provide a full range of diagnostic testing to support bird health, welfare, and compliance. Our laboratory offers fast, reliable testing including Salmonella culture and serotyping, total viable counts, water hygiene, and worm egg counts.
-

Salmonella
This test follows ISO 6579-1, and detects motile Salmonella species using a selective agar called MSRV (Modified Semi-solid Rappaport-Vassiliadis). Complies with the National Control Plan regulations. This method is based upon culturing Salmonella, it will also involve the confirmation of any suspect results and as such the duration of this test can take between 3 and 7 days.
This testing involves growing bacteria from samples in a controlled laboratory environment, allowing accurate confirmation of the presence or absence of Salmonella.
Regular Salmonella culture testing helps protect flock health, maintain retailer assurance schemes, and support compliance with industry regulations.
-

Serotyping
Serotyping is a method used to determine the group of Salmonella that has been detected, or where possible identification down to the specific serotype. Serotyping is performed on all suspect Salmonella obtained or received by the laboratory. Serotyping will provide a result of serogroup, or where possible down to the specific Salmonella strain. Method based upon ISO 6579-3.
-

Salmonella Lion Code Egg Testing
This test follows Lion Code requirements as set out in Appendix CC, for the detection of Salmonella on the outside shell surface and the internal contents of whole eggs. A minimum of 20 eggs are required per individual flock. This method is based upon culturing Salmonella, it will also involve the confirmation of any suspect results and as such the duration of this test can take between 3 and 7 days.
-

Water Hygiene
This procedure is for the simultaneous analysis of Total Viable Count (TVC) and Coliforms in water.
Total Viable Count (Aerobic) gives a quantitative number of colony-forming units (CFUs) of all aerobic bacteria present per ml of sample, determined by incubating the sample on a nutrient-rich agar medium under aerobic conditions.
The Coliform test follows the same premise as the TVC test, however it gives a quantitative number of colony - forming units of the specific coliform bacteria present per ml of sample.
-

Egg and Worm Counts
This test is based upon a modified McMaster method and provides a quantitative estimate of the number of coccidial oocysts and nematode eggs in one gram of faeces, is also able to estimate the number of those nematode eggs which are of capillaria species.
-
Vaccine Differentiation
This test is performed when Salmonella enteritidis has been detected. ASAP agar is used to determine if the strain detected is Salmovac 440 Vaccine strain, or a Wild non-Salmovac strain.
Submission Forms
For your convenience, we also provide downloadable submission forms for key tests, including Salmonella, TVC and water hygiene, and worm egg counts. Simply complete the relevant form and send it with your samples to ensure quick and accurate processing.
Egg Testing
Layer Salmonella
Hatchery Salmonella
Broiler Salmonella
Breeder Salmonella
General Sample
Get in touch
For more information about our testing services or to discuss your specific requirements, please get in touch with our team. We’re here to help you choose the right tests, guide you through the submission process, and provide expert support for all your laboratory needs. Click the buttons below to either contact us directly or visit our ‘Help and Advice’ page for further guidance and resources.